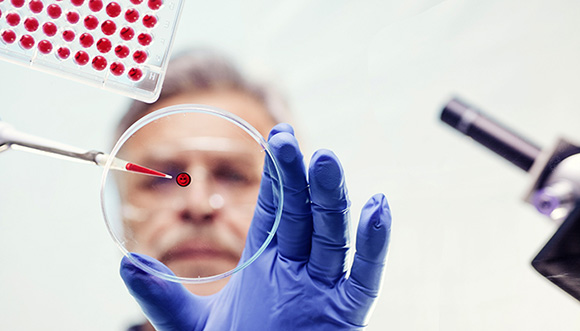

苹果更新四大OS系统
北京时间6月14日消息,本届苹果WWDC开发者大会并没有外界期待的硬件发布,但在软件方面的更新仍有不少看点。iOS、macOS(OS X更名)、watchOS、tvOS均有更新,在移动设备、桌面办公、可穿戴设备、家庭娱乐四大领域继续完善部署。
演讲开始后库克宣布开发者数量达到1300万,比去年新增200万。截至目前,通过App Store,应用下载量超过1300亿,直接向开发者支付了超过500亿美元。
iOS 10在锁屏、Siri、地图等几个方面进行了重要更新,将在秋天推送给所有的用户。在本届WWDC开发者大会上OS X正式更名macOS,还可以用Siri搜索然后Apple Pay一下。Apple Watch已经发布两年之久,本次WWDC主要是在系统方面发布全新watchOS 3,例如在细节上进行修改,响应速度将明显提升,速度明显提升,比2.0版本快7倍。
此外,苹果称,去年秋天推出下一代的tvOS,目前Apple TV上已经有超过1300个视频频道,6000个原生App。还有超过100个直播频道将在下个月上线。
因整顿商业推广服务 百度下调Q2营收预期
6月14日消息,百度今日发布财务公告,将2016年Q2预期营收总额从前期预测的201.1亿元(约合31.19亿美元)到205.8亿元(约合31.92亿美元)之间,调整为181亿元(约合28.07亿美元)到182亿元(约合28.23亿美元)之间。
百度方面表示,此次预期的季度营收受到影响,与百度从5月开始全面整顿商业推广服务密切相关;百度在这次整改中,调整和优化了付费搜索的规则,建立了一个以客户信誉度为主的排序机制,下线了不符合资质要求的2518家医疗机构、1.26亿条医疗信息,并全面实现搜索页面商业推广信息占比低于30%。
百度董事长兼首席执行官李彦宏认为,百度采取的措施将进一步增强互联网线上线下生态的健康、安全和可信赖程度。同时,这些举措也将为百度带来长期收益和回报。
LinkedIn CEO公开信解释被微软收购原因
北京时间6月13日晚间消息,在微软宣布以262亿美元的价格收购LinkedIn之后,LinkedIn CEO杰夫·维纳(Jeff Weiner)随后向全体员工发送邮件,解释被收购的原因。
杰夫·维纳称,在和萨蒂亚·纳德拉(Satya Nadella)坐下来讨论如何展开合作的很久之前,曾公开分享过纳德拉的工作如何迅速转变了微软的战略和文化。他认为很难看见,如此规模的公司能做出基础性的改变。
当纳德拉首次提出收购LinkedIn的想法时,他表示,最重要的是我们需要就两件事达成一致:目标和架构。从本质上来说,都在试图去做同一件事,但从两个不同方面入手。LinkedIn专注于职业网络,而微软则是职业云。
杰夫·维纳称表示,双方都意识到,将这些资产整合在一起将带来独特的优势,并有可能释放某些巨大的机会。
雅虎拍卖3000项专利 约占其专利总数一半
雅虎近日委托专利代理机构Broker Stone IP拍卖其3000项专利。
本次出售的3000项专利约占雅虎专利总数的一半,包括网页搜索和在线广告相关的基础专利。此外,雅虎在出售其互联网业务时,将把另外1100件美国专利作为搭售内容赠送。不过雅虎还留有1000多项专利自用,以支撑其剩余业务的发展。
雅虎的很多专利属于互联网领域最具价值的基础专利。在本次出售的3000项专利中,有一项“超级专利”——US 6269361,该专利的引用值高达1670,属于竞价排名搜索领域最核心的基础专利。该专利来自Goto.com,后者是所有竞价排名搜索引擎的鼻祖公司,2003年被雅虎收购。
雅虎曾通过该专利起诉Google,并在2004年迫使Google达成和解。作为和解条件,雅虎获得了270万股Google股票。当时,Google股价为110美元,雅虎获得的总价约3亿美元左右。
中国移动与诺基亚合作布局5G
6月13日消息,诺基亚宣布与中国移动签署合作框架协议,通过提供无缝联网功能,帮助中国移动实现其网络向灵活云网络基础设施的迁移。该协议将为期一年,价值高达13.6亿欧元。根据协议,将由诺基亚通信中国和上海贝尔共同为中国移动提供服务,将为中国移动部署5G就绪的 AirScale基站解决方案。
签约仪式于中德经济技术合作论坛期间举行,根据协议,诺基亚将为中国移动部署5G就绪的AirScale基站解决方案,该方案能够使多种无线技术在一座基站中同时运行,并能够提供支持5G速率及满足IoT需求的无限的可扩展性。
诺基亚还将提供固定接入、IP路由及光传输、客户体验管理、运营支撑系统(OSS)、第三方产品及全球服务支持,包括移动无线接入的附加元素和核心组件。




评论